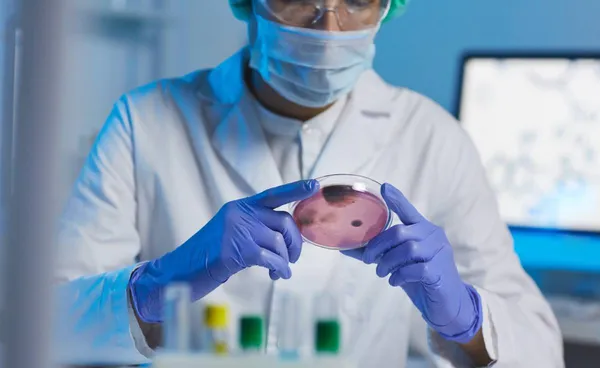

การมีลูกยากเป็นปัญหาที่พบได้บ่อยในคู่สมรสปัจจุบัน แต่ด้วยความก้าวหน้าทางการแพทย์ “การแช่แข็งตัวอ่อน” หรือที่เรียกว่า (Embryo Freezing) จึงกลายมาเป็นเทคโนโลยีสำคัญที่ช่วยสานฝันของหลายครอบครัวให้เป็นจริง
คือส่วนหนึ่งในขั้นตอนการรักษาภาวะมีบุตรยาก เป็นการรักษาคุณภาพของตัวอ่อนให้คงสภาพเช่นเดิมเพื่อการมีบุตรในอนาคต โดยกระบวนการที่เกี่ยวข้องกับการใช้ความเย็น เพื่อเก็บรักษาไข่ที่ปฏิสนธิ แล้วรอย้ายกลับเข้าสู่โพรงมดลูกในระยะต่อไปในกระบวนการทำเด็กหลอดแก้ว (IVF/ICSI) ซึ่งช่วยเพิ่มอัตราการตั้งครรภ์จากการเลือกย้ายตัวอ่อนที่สมบูรณ์ภายหลังการตรวจวินิจฉัยความผิดปกติของโครโมโซมหรือโรคที่ถ่ายทอดทางพันธุกรรมแล้ว
กระบวนการแช่แข็งตัวอ่อนเป็นอย่างไร
การแช่แข็งตัวอ่อน (Embryo freezing) เป็นการเก็บรักษาตัวอ่อน จากกระบวนการทำเด็กหลอดแก้ว (IVF/ICSI) ให้คงสภาพเช่นเดิมเพื่อการมีบุตรในอนาคต โดยการหยุดการทำงานของเซลล์ตัวอ่อนไว้ด้วยวิธีการลดอุณหภูมิของเซลล์ลงโดยใช้วิธีการแช่แข็งแบบผลึกแก้ว หรือ "Vitrification" โดยใช้สารป้องกันการเกิดผลึกน้ำแข็งและการลดอุณหภูมิของเซลล์ตัวอ่อนอย่างรวดเร็ว ทำให้ลดการเกิดผลึกน้ำแข็งขึ้นภายในเซลล์ และสามารถเพิ่มอัตราความสำเร็จของการแช่แข็งและละลายตัวอ่อน เพื่อให้ได้ตัวอ่อนที่มีคุณภาพดีหลังการละลาย

สรุปข่าว
การมีลูกยากเป็นปัญหาที่พบได้บ่อยในคู่สมรสปัจจุบัน แต่ด้วยความก้าวหน้าทางการแพทย์ “การแช่แข็งตัวอ่อน” หรือที่เรียกว่า (Embryo Freezing) จึงกลายมาเป็นเทคโนโลยีสำคัญที่ช่วยสานฝันของหลายครอบครัวให้เป็นจริง
คือส่วนหนึ่งในขั้นตอนการรักษาภาวะมีบุตรยาก เป็นการรักษาคุณภาพของตัวอ่อนให้คงสภาพเช่นเดิมเพื่อการมีบุตรในอนาคต โดยกระบวนการที่เกี่ยวข้องกับการใช้ความเย็น เพื่อเก็บรักษาไข่ที่ปฏิสนธิ แล้วรอย้ายกลับเข้าสู่โพรงมดลูกในระยะต่อไปในกระบวนการทำเด็กหลอดแก้ว (IVF/ICSI) ซึ่งช่วยเพิ่มอัตราการตั้งครรภ์จากการเลือกย้ายตัวอ่อนที่สมบูรณ์ภายหลังการตรวจวินิจฉัยความผิดปกติของโครโมโซมหรือโรคที่ถ่ายทอดทางพันธุกรรมแล้ว
กระบวนการแช่แข็งตัวอ่อนเป็นอย่างไร
การแช่แข็งตัวอ่อน (Embryo freezing) เป็นการเก็บรักษาตัวอ่อน จากกระบวนการทำเด็กหลอดแก้ว (IVF/ICSI) ให้คงสภาพเช่นเดิมเพื่อการมีบุตรในอนาคต โดยการหยุดการทำงานของเซลล์ตัวอ่อนไว้ด้วยวิธีการลดอุณหภูมิของเซลล์ลงโดยใช้วิธีการแช่แข็งแบบผลึกแก้ว หรือ "Vitrification" โดยใช้สารป้องกันการเกิดผลึกน้ำแข็งและการลดอุณหภูมิของเซลล์ตัวอ่อนอย่างรวดเร็ว ทำให้ลดการเกิดผลึกน้ำแข็งขึ้นภายในเซลล์ และสามารถเพิ่มอัตราความสำเร็จของการแช่แข็งและละลายตัวอ่อน เพื่อให้ได้ตัวอ่อนที่มีคุณภาพดีหลังการละลาย
จากนั้นทำการเก็บรักษาไว้ในไนโตรเจนเหลว ที่อุณหภูมิ -196องศาเซลเซียส จนกว่าจะมีการนำตัวอ่อนมาละลายเพื่อทำย้ายสู่โพรงมดลูกต่อ ในระยะเวลาที่ต้องการ นอกจากนี้การเลือกตัวอ่อนเพื่อทำการแช่แข็งมีความสำคัญต่อคุณภาพตัวอ่อนหลังการละลายระยะของตัวอ่อนสามารถทำการแช่แข็งได้ในช่วงระยะวันที่ 1-6 ของตัวอ่อน โดยพิจารณาจากปัจจัยต่าง ๆ เช่น จำนวน เกรดตัวอ่อน หรือ การตรวจวินิจฉัยพันธุกรรมก่อนย้ายตัวอ่อน (PGT) หรืออื่น ๆ
การแช่แข็งตัวอ่อน มีข้อดีอย่างไร?
1. เพิ่มโอกาสในการตั้งครรภ์
การใส่ตัวอ่อนที่ผ่านการแช่แข็งกลับเข้าโพรงมดลูกให้ผลสำเร็จสูงกว่าการใส่ตัวอ่อนในรอบกระตุ้นไข่ เนื่องจากในรอบกระตุ้น ร่างกายจะมีระดับฮอร์โมนสูงผิดปกติ ส่งผลต่อความพร้อมของเยื่อบุโพรงมดลูก แต่การแช่แข็งตัวอ่อนช่วยให้สามารถใส่ตัวอ่อนในสภาวะที่ร่างกายสมดุล พร้อมรองรับการตั้งครรภ์ได้ดียิ่งขึ้น
2. ลดโอกาสเกิดภาวะแทรกซ้อน
การแช่แข็งตัวอ่อนช่วยลดภาวะแทรกซ้อน เช่น ภาวะรังไข่ถูกกระตุ้นเกิน อาการอืดแน่นท้อง ภาวะท้องบวมน้ำ หรือโปรตีนในเลือดต่ำ ทำให้กระบวนการรักษาปลอดภัยยิ่งขึ้นสำหรับผู้หญิงที่มีภาวะเสี่ยง

3. ลดความเสี่ยงโรคทางพันธุกรรม
การแช่แข็งตัวอ่อนช่วยเพิ่มเวลาในการตรวจพันธุกรรมตัวอ่อน (Preimplantation Genetic Testing – PGT) เพื่อค้นหาความผิดปกติที่อาจส่งผลต่อสุขภาพทารก การคัดเลือกตัวอ่อนที่สมบูรณ์จะช่วยเพิ่มโอกาสในการมีลูกที่แข็งแรง ปลอดโรคทางพันธุกรรม
4. วางแผนการตั้งครรภ์ได้ตามต้องการ
คู่สมรสที่ยังไม่พร้อมมีบุตรสามารถเก็บรักษาตัวอ่อนไว้ และเลือกช่วงเวลาที่เหมาะสมสำหรับการตั้งครรภ์ในอนาคต ไม่ว่าจะด้วยเหตุผลด้านอาชีพ สุขภาพ หรือแผนชีวิตส่วนตัว
การแช่แข็งตัวอ่อน เป็นทางเลือกที่ปลอดภัย และมีประสิทธิภาพสูงในการรักษาภาวะมีบุตรยาก ช่วยเพิ่มโอกาสตั้งครรภ์ ลดความเสี่ยงจากภาวะแทรกซ้อน และโรคทางพันธุกรรม พร้อมทั้งให้ความยืดหยุ่นในการวางแผนชีวิต
- โลกร้อนกระทบคนท้อง วิจัยชี้เสี่ยงคลอดก่อนกำหนด
- "ตั้งครรภ์" แล้วป่วยด้วย "โรคไบโพลาร์" ไม่รักษาให้ดี จะเกิดอะไรขึ้น
- โรงงาน “รีดไข่” มนุษย์ หญิงไทยตกเป็นเหยื่อ เซ่นสวรรค์อุ้มบุญจอร์เจีย
- แพท วงเคลียร์ คลอดลูกคนแรกเป็นของขวัญปีใหม่ ตั้งชื่อน่ารัก "เรอารฎา"
- รัฐบาล แก้ปัญหาตั้งครรภ์ ทำให้แม่วัยรุ่นอายุ 15-19 ปี ลดลง
- พริม พริมา อวดท้องแก่ 37 สัปดาห์ เตรียมนับถอยหลังพบหน้าลูกสาว
- ศรีริต้า-กรณ์ ณรงค์เดช ตื่นเต้น! นับถอยหลังพบหน้าลูกสาวตัวน้อย
ที่มารูปภาพ : Envato

